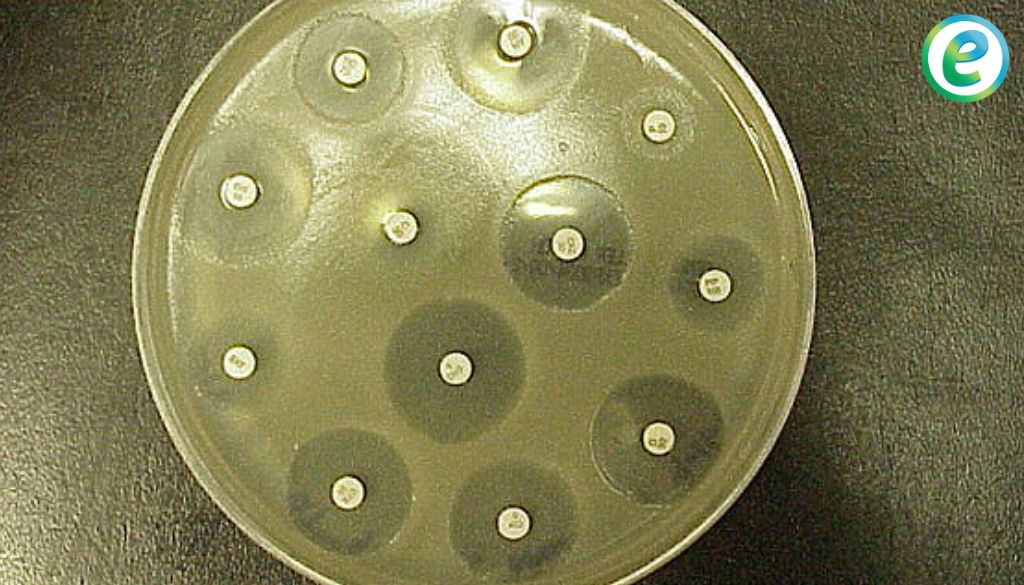

Resistencia antimicrobiana reducirá esperanza de vida en 1,8 años para 2035

El Grupo de Líderes Mundiales sobre la Resistencia a los Antimicrobianos (RAM ) ha publicado un informe que advierte sobre las graves consecuencias de la inacción frente a este problema creciente. El estudio económico presentado por el grupo confirma que la resistencia a los antimicrobianos no solo tiene un costo humano significativo, sino que también […]
Estudio revela vínculo entre pobreza y uso inadecuado de antibióticos

Un reciente estudio publicado en la revista The Lancet Global Health ha revelado que la pobreza es un factor clave en la resistencia a los antimicrobianos en países de ingresos bajos y medianos. El Consorcio Holistic Approach to Unravelling Antimicrobial Resistance (HATUA) llevó a cabo una investigación que incluyó entrevistas a 6827 pacientes en Kenia, […]
Nuevo informe OMS destaca aumento en resistencia antimicrobiana

Un nuevo informe de la Organización Mundial de la Salud (OMS), pone de manifiesto elevados niveles de resistencia en bacterias causantes de septicemias potencialmente mortales, así como una creciente resistencia a los tratamientos en varias bacterias que provocan infecciones comunes entre la población, según se desprende de los datos comunicados por 87 países en 2020. […]
¿Cómo elegir el mejor antibiótico para tratar a mi paciente?
Autora: Dra. Andreina Martínez Paulino Las pruebas de sensibilidad o antibiogramas determinan la susceptibilidad de un microorganismo a los antimicrobianos, a partir de su exposición a una concentración estandarizada. Las pruebas de sensibilidad pueden hacerse para bacterias, hongos o virus. Las pruebas de sensibilidad se realizan in vitro, y no toman en cuenta los factores que […]